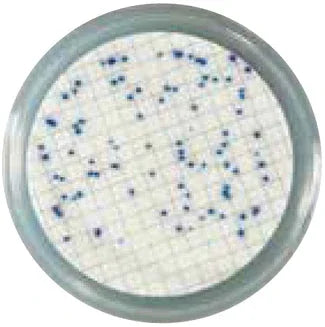
A Beginner’s Guide to Faster, Easier Water Testing with Liofilchem® Easy Dry™ - Kormay Biomedicals store

KORMAY BLOG

How Pharmaceutical Companies Use Liofilchem Media for Sterility Testing
Ensuring that medicines are safe and free of any harmful microorganisms is critical in the pharmaceutical world. The sterility testing of pharmaceutical products USP sets the standard for this process, with Liofilchem media playing a vital role in upholding quality and safety for patients everywhere.

Contact Plates vs. Dipslides: Which Is Better for Your Sanitation Program?
Curious about keeping your facility spotless and your sanitation program effective? When it comes to monitoring surface hygiene, two popular tools—contact plates and dipslides—often enter the conversation. Which one truly fits your needs? Let's break down the differences so you can make an informed choice.

Why Is It Important to Test Water Quality? Even for Products Without Water
When thinking about water quality testing, most people imagine drinking water or beverages. But what if the end product doesn’t seem to contain water? Understanding why it is important to test water quality can uncover hidden risks and ensure safety in countless industries.

How Lab Data Shapes the Search for Effective, Targeted Antibiotics
Ever wondered how doctors decide which antibiotic to prescribe—and for how long—when you’re sick with a bacterial infection? The answer lies in an intricate process called antibiotic susceptibility testing, which tailors treatment to your specific needs for faster recovery and fewer side effects.
A Beginner’s Guide to Faster, Easier Water Testing with Liofilchem® Easy Dry™
Water quality matters—whether you’re ensuring safe drinking water or checking environmental samples, accuracy and efficiency are key. Liofilchem® Easy Dry™ culture media streamlines the traditional process, making water testing faster, cleaner, and simpler for everyone from lab techs to field researchers.

How Mycotoxin Testing Can Save Lives: Protecting Against Aflatoxin in Food
Aflatoxin in food is an invisible health threat lurking in kitchens, pantries, and animal feed worldwide. Fortunately, regular mycotoxin testing can help protect your family, pets, and livestock from dangerous toxins before they cause lasting harm.

How Ready to Use Culture Media Plates Can Save You Time and Money
Running a laboratory or quality testing process involves many critical steps, but preparing culture media shouldn’t be your biggest headache. Ready to use culture media plates are rapidly becoming the smart choice, offering both cost savings and streamlined workflows for organizations big and small.
